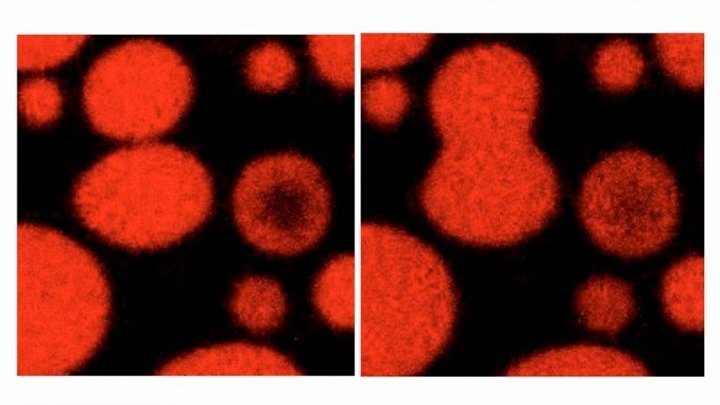

ciencia
Revelan cómo suprime tumores el gen p53
El estudio, liderado por investigadores del CONICET, se centró en la proteína codificada por el gen P53 y puede tener múltiples implicancias terapéuticas y de diagnóstico.
Conocido como el “guardián del genoma”, p53 es un gen supresor de tumores, ya que da origen a una proteína que controla la división celular y que, ante lesiones en el ADN (producidas por agentes como rayos UV o compuestos químicos del cigarrillo), puede hacer que la célula se autodestruya para evitar su proliferación de forma descontrolada. Sin embargo, en el 50 por ciento de todos los cánceres, p53 está mutado y produce proteínas en la que esa función protectora está inactiva; incluso, cierto tipo de mutaciones contribuyen a que, además, empiecen a acumularse y se formen depósitos de proteínas anómalas (“amiloides”) que pueden promover la evolución tumoral.
Ahora, un estudio liderado por el investigador del CONICET Gonzalo de Prat Gay determinó el mecanismo por el cual p53 forma estos amiloides, y comprobó que es sorprendentemente similar a lo que ocurre en el cerebro en enfermedades como el Alzheimer y el Parkinson. Lo hace a través de los llamados “condensados biomoleculares”, un concepto revolucionario dentro de la biología y que define a ciertas estructuras efímeras y relevantes en el interior de las células, que recuerdan a las gotas que se forman en una vinagreta, donde dos líquidos de distintas propiedades conviven sin mezclarse.